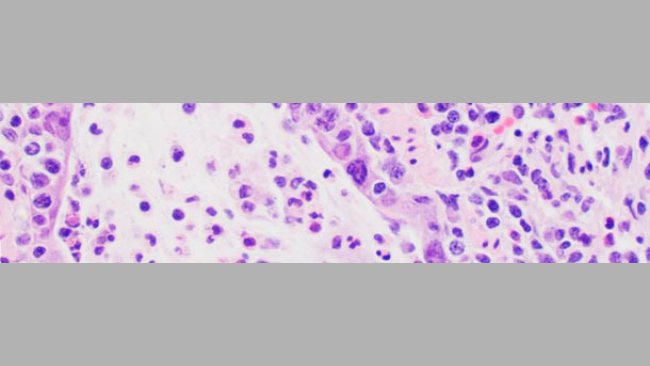
Lesiones microscópicas compatibles con la infección por influenza, incluyen necrosis del epitelio bronquiolar donde el virus se replica

Implicações do dilema da recombinação do vPRRS
As medidas de controlo da PRRS também reduzem as oportunidades de diferentes vírus no campo se recombinarem e gerarem estirpes mais agressivas.
Notícias, eventos e reportagens da actualidade do sector suinícola
Os eventos relacionados com o sector suinícola existem a nível mundial
Fórum de discussão sobre temas dos suínos
Um resumo semanal das novidades da 3tres3.com.pt
Um boletim periódico de notícias sobre o mundo suinícola
A saúde dos suínos: notícias e artigos sobre PRRS, PCV2, biossegurança, etc., guia de doenças do porco, atlas de patologia, casos clínicos...
Como realizar uma necrópsia num porco, passo a passo, numa forma muito visual e prática.
Toda a informação sobre a Peste Suína Africana (PSA) na 3tres3,com.pt e em links externos
Descrição das doenças e afecções mais importantes nos suínos
Descrição fotográfica das lesões mais significativas dos suínos
Ferramenta para diagnosticar doenças nos suínos
Calcula a quantidade de medicamento a incorporar na água quando usamos um dosificador de fluxo
Um resumo semanal das novidades da 3tres3.com.pt
Preços do porco por países. Produção e comércio de carne de porco. Notícias do mercado do porco e das matérias-primas
As últimas cotações e a evolução histórica dos mercados mais importantes do suíno
Calcula o teu custo de produção, compara-o com o custo de referência e avalia como cada parâmetro afecta o custo de produção total e a margem
Dados e tendências do efectivo, produção e comércio de carne.
Dados de produção e comércio mundial das principais matérias-primas
Um resumo semanal das novidades da 3tres3.com.pt
Artigos sobre nutrição e alimentação de suínos, características das matérias primas e dos aditivos para suínos e preços das matérias-primas
Fichas técnicas das principais matérias-primas e aditivos. Incluem informação de valores nutricionais, produção e comércio, estudos recentes,...
Dados de produção e comércio mundial das principais matérias-primas
Utilize esta ferramenta para diagnosticar problemas com o Índice de Conversão. Clique no diagrama de fluxo ou nos botões dentro do texto para navegar pelas diferentes partes da ferramenta.
Um resumo semanal das novidades da 3tres3.com.pt
Um boletim mensal de notícias sobre a nutrição dos suínos
Artigos sobre genética e reprodução nos suínos: selecção genética, genómica, inseminação artificial, uso de hormonas...
Compare dados produtivos, calcule os lugares de porcas, transição e engorda e visualize as tarefas no calendário consoante cada tipo de MEB.
Calcula a entrada de porcas ao iniciar uma exploração, para aumentar o seu efectivo ou para calcular a reposição de uma exploração em funcionamento
Um resumo semanal das novidades da 3tres3.com.pt
Maneio e gestão das suiniculturas e organização do trabalho em cada uma das fases de produção: maneio na gestação, engorda, maneio em bandas...
Compare dados produtivos, calcule os lugares de porcas, transição e engorda e visualize as tarefas no calendário consoante cada tipo de MEB.
Calcula o teu custo de produção, compara-o com o custo de referência e avalia como cada parâmetro afecta o custo de produção total e a margem
Um resumo semanal das novidades da 3tres3.com.pt
Desenho de instalações e equipamentos para suiniculturas: desenho de pavilhões, climatização, sistemas de alimentação, etc. Comparadores de equipamiento.
Que equipamento necessito para a minha exploração? Apresentamos-te diferentes equipamentos para que possas escolher.
Calculadora da pegada ambiental ao longo da cadeia de valor dos suínos
Um resumo semanal das novidades da 3tres3.com.pt
Aqui encontrarás os autores especializados em suíno que colaboram na 3tres3 com informação do seu curriculum
POSIÇÃO ACTUAL
Professor Assistente: Departamento de Veterinaria Diagnóstico e Produção Animal "College of Veterinary Medicine", Universidade Estatal de Iowa, Ames, IA 50011
GRAUS
Ph.D. 2012 Universidade Estatal de Iowa, Ames. Microbiologia Veterinária
M.S. 2008 Universidade Estatal de Iowa, Ames. Microbiologia Veterinária
D.V.M. 1994 Universidade Estatal de Iowa, Ames. Doutoramento Medicina Veterinária
B.S. 1990 Universidade Estatal de Iowa, Ames. Ciência Animal
EXPERIÊNCIA PROFISSIONAL
2008-Actual: Professor Assistente/Diagnostico, Medicina Veterinária Diagnóstico e Produção Animal, "College of Veterinary Medicine", Universidade Estatal de Iowa, Ames.
2006-2008: Médico Veterinário, USDA-ARS National Animal Disease Center, Ames, IA
1994-2006: Veterinário e Partner, Marcus/Remsen Veterinary Clinic, PLC, Marcus, IA
CREDENCIAIS ACADÉMICAS
Docente do Departamento de Diagnóstico Veterinário e Produção Medicina Animal, Faculdade de Medicina Veterinária da Universidade Estadual de Iowa.
Patologista de diagnóstico no Laboratório de Diagnóstico Veterinário da Faculdade de Medicina Veterinária da Universidade Estadual de Iowa.
Curriculum actualizado: 12-Nov-2014

As medidas de controlo da PRRS também reduzem as oportunidades de diferentes vírus no campo se recombinarem e gerarem estirpes mais agressivas.

A mutação e a evolução genética do vPRRS podem ocorrer em todos os genes. Ao contrário da ORF5, que representa apenas cerca de 4% do genoma do vPRRS, o NGS pode recuperar todo o genoma do vPRRS para utilização em investigação epidemiológica.
À medida que a ecologia do IAv se tornou mais complexa, devido à mutação e recombinação viral, foram surgindo novos tipos de amostras e testes diagnósticos para detectar ou diagnosticar infecções por gripe em porcos.
Um resumo semanal das novidades da 3tres3.com.pt
faz login e inscreve-te na lista
Bem-vindo à 3tres3
Ligue-se, partilhe e relacione-se com a maior comunidade de profissionais do sector suinícola.
Já somos 195452 Utilizadores!
Regista-teJá é membro?



